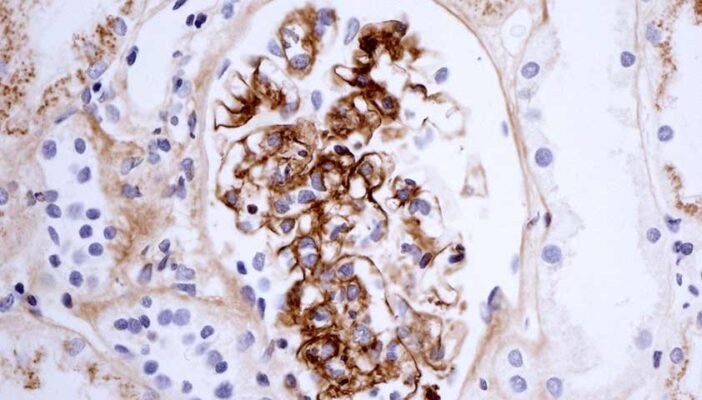
Хвороба Берже: симптоми, діагностика та сучасні методи лікування

- Хвороба Берже: Загадка Сучасної Медицини
- Що таке Хвороба Берже?
- Перше знайомство з симптомами
- Причини та чинники ризику
- Що провокує хворобу?
- А як щодо діагностики?
- Методи лікування: Що далі?
- Терапія для всіх?
- Роль харчування в лікуванні
- Що є, щоб допомогти ниркам?
- Соціальні аспекти та життя з хворобою
- Психологічна підтримка
- Групи підтримки
- Майбутнє та дослідження
- Клінічні випробування
- Дослідження та спостереження
Хвороба Берже: Загадка Сучасної Медицини
Хвороба Берже, також відома як IgA-нефропатія, хвилює медиків у всьому світі. Складна та, деколи, незрозуміла. Для багатьох – це лише слова… Але для тисяч – реальність. Сьогодні спробуємо зануритися глибше в цю тему. Що це таке? Чому вона виникає?
Що таке Хвороба Берже?
Кожен чув про хворобу, але не всі розуміють, що насправді відбувається всередині організму. Хвороба Берже – це розлад, при якому антитіла IgA (імуно-глобулін А) накопичуються в нирках, викликаючи запалення. Ой, думаєте це щось просте? Зовсім ні. Це процес, через який організму важко функціонувати.
Перше знайомство з симптомами
- Кров у сечі – часто це перший і найпомітніший симптом.
- Біль у боці, спині або животі
- Набряки – ніг, рук, обличчя
- Підвищена втомлюваність
Ось так… Одного дня людина може відчути щось не те. Звісно, багато хто спочатку не розуміє, що це може бути серйозно.
Причини та чинники ризику
Що провокує хворобу?
І тут починається найскладніше. Імунна система. Саме вона починає поводитися інакше, ніж зазвичай. Причини? Та хто ж їх назве точно. Але відомо кілька основних чинників:
- Генетика – часто передається у родині.
- Вірусні інфекції – така собі спускова кнопка.
- Інші захворювання, такі як целіакія.
Дивує? Здається, все просто, але…
А як щодо діагностики?
Знайти відповідь на запитання «Чому саме я?» – завдання не з легких. Для багатьох це триває роками.
- Лабораторні аналізи: Виключно точність.
- Біопсія нирок: Так, і ця маленька процедура має велике значення.
Техніка, яка вимірює рівень альбуміну, знову і знову доводить, що точність – це ключ.
Методи лікування: Що далі?
Чесно кажучи, боротьба з хворобою Берже вимагає від пацієнта багато. Нерідко – постійного контролю.
Терапія для всіх?
Хто хоч раз зіштовхувався з хворобою Берже, знає — лікування може бути різним:
- Стероїди: допомагають зменшити запалення.
- Імуносупресивні препарати: стабілізують імунну систему.
- Зміни в дієті: часто, ця порада виявляється рятівною.
Експерименти, звичайно, не найкраща ідея. Бо медицина, як і життя, сповнена несподіванок.
Роль харчування в лікуванні
Давайте поговоримо про їжу. Важливо підібрати дієту. І тут — як лотерея.
Що є, щоб допомогти ниркам?
- Обмеження солі: зменшує набряки.
- Менше білка: основний ворог при нефропатії.
- Вода, вода, й ще раз вода: гартує як ніхто.
Головне – слухати себе. Що мені справді потрібно?
Соціальні аспекти та життя з хворобою
Життя з хворобою Берже не лише фізичне випробування, але й емоційне… Сім’я, друзі, спільнота – всі вони грають ключову роль.
Психологічна підтримка
Знаєте, іноді розмова може діяти краще, ніж ліки. Тому важливо знати, з ким можна поговорити. Психологи, підтримка родини, навіть книжки… Чому б не спробувати?
Групи підтримки
Спільнота – це ще один шанс. Групи підтримки, де збираються люди з схожими проблемами, можуть надихати. Іноді розуміння, що ти не один, підсилює морально.
Майбутнє та дослідження
Наука не стоїть на місці. Ось у чому справа. І, можливо, завтра ми знатимемо більше. Надія залишається, навіть якщо сьогодні здається не так.
Клінічні випробування
- Імунотерапія – перспективні методи.
- Геномні дослідження – вивчають спадковість захворювання.
…в кінці кінців, чи не варто ризикувати заради знань?
Дослідження та спостереження
Медичні центри працюють безперестанку. Ось такі ми, люди. Залишаємося, щоб боротися. Щоб вчитись. Відчувати, що не дивлячись на все, ми на правильному шляху. І так, це про вас.
Завтра, можливо, прийде новий день. І хвороба Берже перестане бути загадкою.






